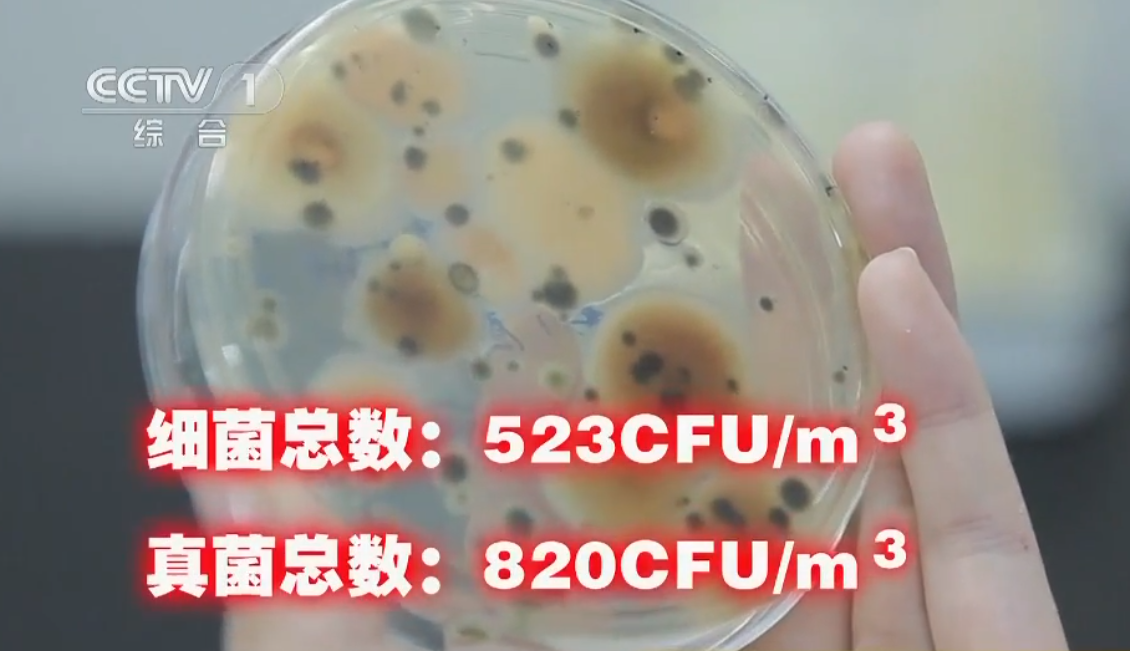
空调压缩机|吹空调吹进了ICU?央视实验演示:空调究竟有多“脏”?大家要警惕

文章图片

文章图片

文章图片

文章图片

文章图片

文章图片

文章图片

文章图片
文章图片

文章图片

文章图片
炎炎夏日 , 白天骄阳似火 , 晚上闷热难当 , 许多人恨不得24小时都待在空调房里 , 甚至网上有人这样调侃道:“宁愿在空调下哭 , 也不愿在风扇下笑 。 ”
然而 , 空调在带给人凉爽的同时 , 背后隐藏着“杀机” , 稍不注意 , “续命”空调可能就会变成隐形“杀手” , 央视多次曝光“脏”空调的危害 。
2021年7月 , 湖南长沙一名男子驾驶一辆两个月未开的轿车外出后 , 突然出现高烧、呼吸困难等症状 , 被紧急送进ICU 。
【空调压缩机|吹空调吹进了ICU?央视实验演示:空调究竟有多“脏”?大家要警惕】这名男子被确诊为军团菌感染 , 医生怀疑罪魁祸首是汽车内空调的病菌 。
2021年5月 , 湖北宜昌37岁的李先生因天气炎热 , 开了家中许久未清洗过的空调 , 出现了呼吸急促和严重的呼吸困难 , 在ICU住了一周都没有完全脱离生命危险 。
据接诊医生所述 , 他的病情很有可能与吹空调有关 , 后来查出是军团菌感染 。
为何吹空调会进ICU?日常生活中 , 绝大多数情况下 , 我们在开空调的同时也都会将门和窗关上 。 在密闭性良好的房间 , 室内外空气无法得到交换 , 这就给细菌、病毒等微生物创造了易于繁殖的理想场所 。
我们开空调时 , 空调散热片是空气流动的必经途径 , 如此一来 , 依附在空气中的灰尘、微生物在空调的不断循环下很容易积聚在内部 , 从而滋生致病菌 。
有的人长时间待在空调环境下 , 总会出现一系列不适症状 , 例如头晕、鼻塞、乏力、或皮肤过敏等 , 这类现象在现代医学上称之为“空调病” 。
上文提到的军团菌感染就是其中一种症状 , 军团菌通过空气传播 , 主要攻击的是人体的肺部 , 一旦感染 , 来势汹汹 。
由于空调长时间不清洗 , 在开空调时附在内部的病菌随着空调风吹出 , 人体吸入后沉积在呼吸道中 。
专家建议 , 为了尽可能减少空调微生物污染的危害 , 最好定期清洗空调 。 然而很多人并不当回事 , 事实上 , 外表看似干净的空调 , 内部环境“触目惊心” 。
空调究竟有多“脏”?空调长期未清洗 , 微生物超标会导致什么样的后果?网上有传闻说:空调三天不洗 , 吹霉一碗米饭!真的有那么可怕吗?
相关经验推荐
- 格力电器|从事家电销售10多年,过来人告诉格力空调与奥克斯空调到底哪个更好
- 亚马逊|空调的除湿模式并不建议长时间开,达到除湿效果后,即可调整的其他舒适的模式
- 芯片|“别吹中国空间站技术多厉害了,你们都被忽悠了,中国的空间站是假的”
- 华为|小米“吹爆”徕卡:整合别人的东西,终究走不长远
- 数据线|手机泡水后,到底该不该“吹干”?维修师傅一句话才懂,大部分人做错了
- |小米12SPro真机体验后,憋了一肚子话想说,不吹不黑聊聊优缺点
- 小米科技|小米12S Ultra真机上手以后,不吹不黑地,谈谈自己的使用感受
- 空调|随身WiFi了解一下?插电即用,1G一分钱,蒲公英X4U体验
- |空调使用不当导致换热器进水怎么办?维修实况分享!
- 芯片|空调有风不凉快是怎么回事,是缺氟吗
